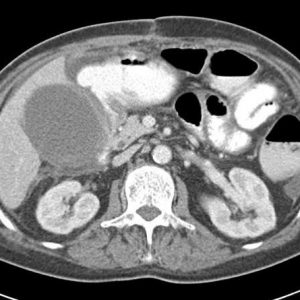
Viêm túi mật

TIÊU HOÁ
Hiển thị 781–800 của 1445 kết quảĐã sắp xếp theo mới nhất
-

Khí tự do ổ bụng
Lượt xem: 516» 30-10-2019 -

Thoát vị nội
Lượt xem: 259» 29-10-2019 -

Chấn thương tụy
Lượt xem: 175» 17-10-2019 -

Viêm túi thừa
Lượt xem: 182» 17-10-2019 -

U tụy
Lượt xem: 163» 15-10-2019 -

U tụy
Lượt xem: 131» 14-10-2019 -

Chấn thương mạc treo
Lượt xem: 178» 13-10-2019 -

U dạ dày
Lượt xem: 138» 12-10-2019 -

Viêm túi mật
Lượt xem: 106» 11-10-2019 -

Viêm túi mật
Lượt xem: 174» 11-10-2019 -

Viêm túi mật
Lượt xem: 202» 11-10-2019 -

Viêm túi mật
Lượt xem: 228» 11-10-2019 -

Viêm túi mật
Lượt xem: 107» 11-10-2019 -

U tụy
Lượt xem: 180» 11-10-2019 -

U đại tràng
Lượt xem: 318» 09-10-2019 -

HCC
Lượt xem: 260» 08-10-2019 -

Xoắn ruột
Lượt xem: 208» 06-10-2019 -

Biloma
Lượt xem: 213» 06-10-2019 -

Viêm ruột thừa
Lượt xem: 213» 03-10-2019 -

Apxe ruột thừa
Lượt xem: 545» 28-09-2019